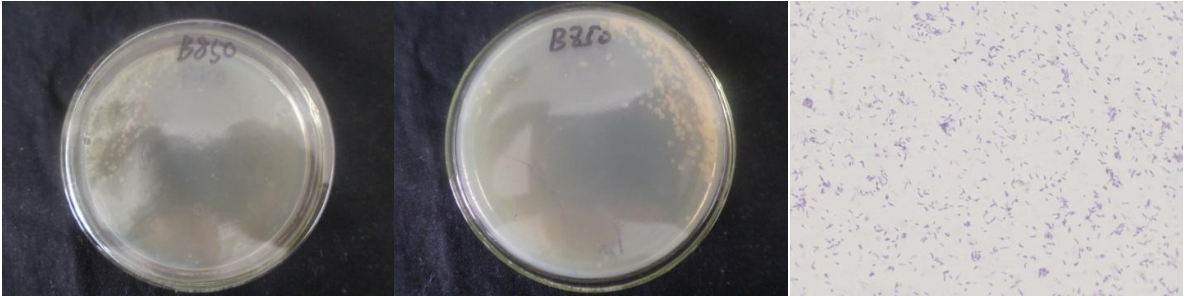

Loading...
| StrainNO | B850 |
| Classification | Pseudomonas |
| 16s rDNA sequence | GGGAGCTTGCTCCCGGATTCAGCGGCGGACGGGTGAGTAATGCCTAGGAATCTGCCTGATAGTGGGGGACAACGTTTCGAAAGG AACGCTAATACCGCATACGTCCTACGGGAGAAAGCAGGGGACCTTCGGGCCTTGCGCTATCAGATGAGCCTAGGTCGGATTAGC TAGTTGGTGAGGTAATGGCTCACCAAGGCGACGATCCGTAACTGGTCTGAGAGGATGATCAGTCACACTGGAACTGAGACACGG TCCAGACTCCTACGGGAGGCAGCAGTGGGGAATATTGGACAATGGGCGAAAGCCTGATCCAGCCATGCCGCGTGTGTGAAGAAG GTCTTCGGATTGTAAAGCACTTTAAGTTGGGAGGAAGGGCAGTAAGCTAATACCTTGCTGTTTTGACGTTACCGACAGAATAAG CACCGGCTAACTTCGTGCCAGCAGCCGCGGTAATACGAAGGGTGCAAGCGTTAATCGGAATTACTGGGCGTAAAGCGCGCGTAG GTGGTTTGTTAAGTTGGATGTGAAAGCCCCGGGCTCaAACCTGGGAACTGCATCCaAAAACTGGCAAGCTAGAGTATGGCAGAG GGTGGTGGAAtTTTCCTGTGTAGCGGTGAAATGCGTAGATATAGGAAGGAACACCAGTGGCGAAGGCGACCACCTGGGCTAATA CTGACACTGAGGTGCGAAAGCGTGGGGAGCAAACAGGATTAGATACCCTGGTAGTCCACGCCGTAAACGATGTCGACTAGCCGT TGGGATCCTTGAGATCTTAGTGGCGCAGCTAACGCATTAAGTCGACCGCCTGGGGAGTACGGCCGCAAGGTTAAAACTCAAATG AATTGACGGGGGCCCGCACAAGCGGTGGAGCATGTGGTTTAATTCGAAGCAACGCGAAGAACCTTACCAGGCCTTGACATGCTG AGAACCTGCCAGAGATGGCGGGGTGCCTTCGGGAACTCAGACACAGGTGCTGCATGGCTGTCGTCAGCTCGTGTCGTGAGATGT TGGGTTAAGTCCCGTAACGAGCGCAACCCTTGTCCTTAGTTACCAGCACGTTATGGTGGGCACTCTAAGGAGACTGCCGGTGAC AAACCGGAGGAAGGTGGGGATGACGTCAAGTCATCATGGCCCTTACGGCCTGGGCTACACACGTGCTACAATGGTCGGTACAAA GGGTTGCCAAGCCGCGAGGTGGAGCTAATCCCATAAAACCGATCGTAGTCCGGATCGCAGTCTGCAACTCGACTGCGTGAAGTC GGAATCGCTAGTAATCGTGAATCAGAATGTCACGGTGAATACGTTCCCGGGCCTTGTACACACCGCCCGTCACACCATGGGAGT GGGTTGCTCCAGAAGTA |
| Strain Morphology Photos | |
| Morphological Description | Colony round;gooseberry yellow;edge neatly;edge bumps;Flat in the middle;wrinkled;slippy;sticky;Bacteriophage Rod-shaped;no spore |